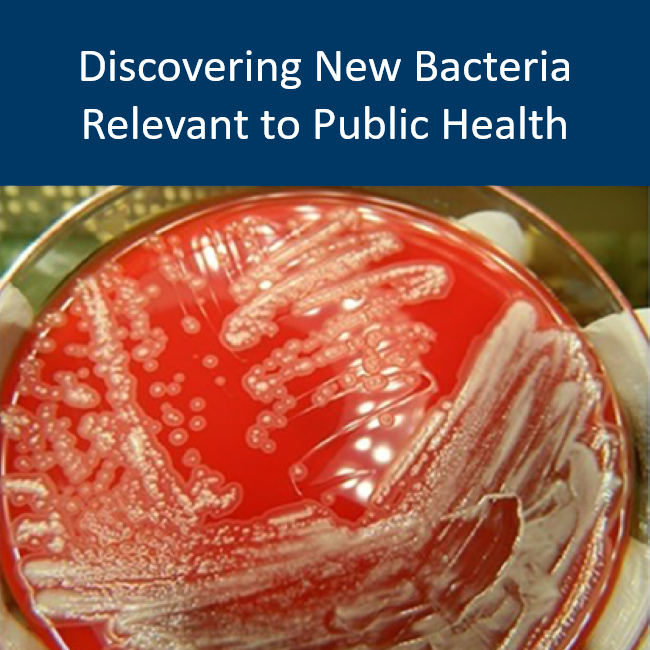

Pathogen Genomics Centers of Excellence
Infectious Disease Projects
Minnesota is one of five states in national initiative
Led by the Public Health Laboratory, the Minnesota Department of Health (MDH) partnered with the University of Minnesota, the Mayo Clinic, and the University of Pennsylvania to be named one of the country’s five Pathogen Genomics Centers of Excellence (PGCoE) by the Centers for Disease Control and Prevention (CDC).
Latest news:
- The People, Pets and Plasmids project has produced a paper linking human and animal cases of infection by multi-drug-resistant organisms. The story was also covered by the University of Minnesota's Center for Infectious Disease Research and Policy: Two investigations reveal how resistant bacteria may have spread from pets to people.
- Minnesota Department of Health scientists used whole-genome sequencing to research recurring infections of Clostridioides difficile (C. diff).
- In investigating a recent increase in gonorrhea cases, Minnesota Department of Health scientists discovered that a rare strain of the bacteria responsible for the disease has become more prevalent.
Read about more at our PGCoE Publications page.
The PGCoE program aims to improve the ability to detect and respond to future infectious disease threats and emergencies. The Minnesotan contingent is working on the following:
![]() | ![]() | ![]() |
![]() | ![]() | ![]() |
![]() | ![]() |
Here is a list of the above, presented for accessibility purposes:
- Combating RSV with Whole-Genome Sequencing
- People, Pets, and Plasmids
- Predicting Salmonella Outbreaks
- Publications from Minnesota PGCoE projects
- Respiratory Illness in Underserved Communities
- Sources of Foodborne Illness Outbreaks
- Using COVID-19 Data to Improve Disease Response
Four other states were accepted into the PGCoE network: Georgia, Massachusetts, Virginia, and Washington. The findings and best practices from all PGCoE projects will be publicly available through the CDC. Please contact the Infectious Disease Laboratory with any questions.